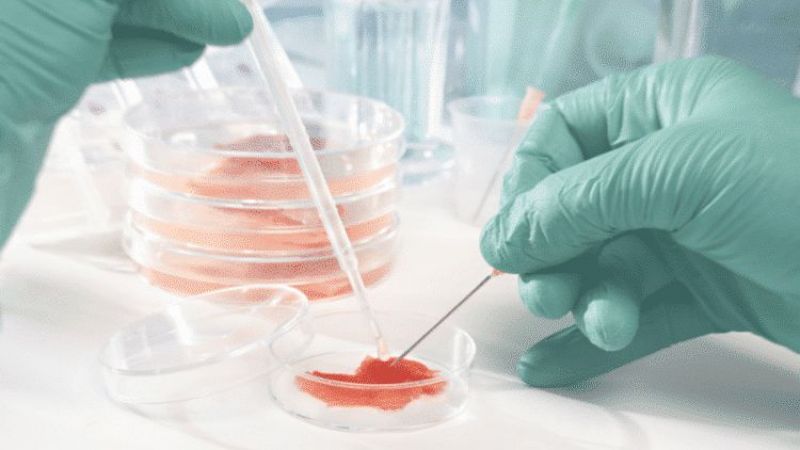

Avustralya Melbourne’den bir grup araştırmacı, laboratuvar ortamındaki 800.000 beyin hücresinin, verilen bir görevi yapabildiğini ispatladı. Bu çalışmaya özel olarak, hücrelerin tenise benzer bir bilgisayar oyunu olan Pong oynaması sağlandı.
Araştırma ekibinin bir sonrası hedefi, beyin hücrelerinin ilaçlardan ve alkolden nasıl etkilendiğini incelemek.
Yeni bir biyoteknoloji firması olan Cortical Labs’ın Bilimsel Çalışmalar Şefi Dr. Brett Kagan, “Aktivitelerini değişmeye zorlayan bir şekilde, canlı biyolojik sinir hücreleri ile etkileşime geçebileceğimizi, ortaya ‘zeka’ benzeri bir sonuç çıkarılabileceğini gösterdik” diye konuştu. Cortical Labs, yeni nesil biyolojik bilgisayar çipleri üretmeyi amaçlayan bir firma.
Dr. Brett Kagan’ın araştırma ekibinde Monash Üniversitesi, RMIT Üniversitesi, University College London ve Kanada İleri Araştırmalar Enstitüsü’nden bilim insanları yer alıyordu.
Araştırmanın önemi ne?Cortical Labs CEO’su Dr. Hon Weng Chong ise yaptığı açıklamada, “DishBrain, insan beyninin nasıl çalıştığını test etmek için basit bir yaklaşım sunuyor. Aynı zamanda epilepsi ve bunama gibi hastalıkların anlaşılması için önemli bir yolun önünü açıyor” diye konuştu.
Bilim insanları bir süredir sinir hücrelerini çoklu elektrot sıralarına yerleştirerek aktivitelerini takip edebiliyor. Ancak bu yeni araştırma ile ilk kez hücreler anlamlı bir şekilde uyarıldı ve yapılandırıldı.
Deney nasıl yapıldı?Deneyin yapılabilmesi için araştırma ekibi, fare embriyolarının beynindeki hücreleri aldı. İnsan beynindeki bazı hücreleri de kök hücrelerden alan ekip, bu hücreleri, onları uyarabilen ve aktivitesini okuyabilen bir mikroelektrot sırasında çoğalttı.
Tenis benzeri oyunun öğretilmesi için; dizinin solundaki veya sağındaki elektrotlar, Dishbrain’e topun hangi tarafta olduğunu söylemek için uyarıldı, topun raket ne kadar uzak olduğu bilgisi ise uzaklık ise sinyallerin frekansıyla bildirildi. Elektrotlardan gelen geri bildirimler, DishBrain’e hücrelerin kendileri raketmiş gibi davranmasını sağlayarak topu nasıl geri döndüreceğini öğretti.
Aşağıdaki videodan, laboratuvar ortamındaki hücrelerin oynadığı oyunun bir kaydını izleyebilirsiniz…
Araştırmadan elde edilen bulgular Neuron dergisinde yayınlandı.






